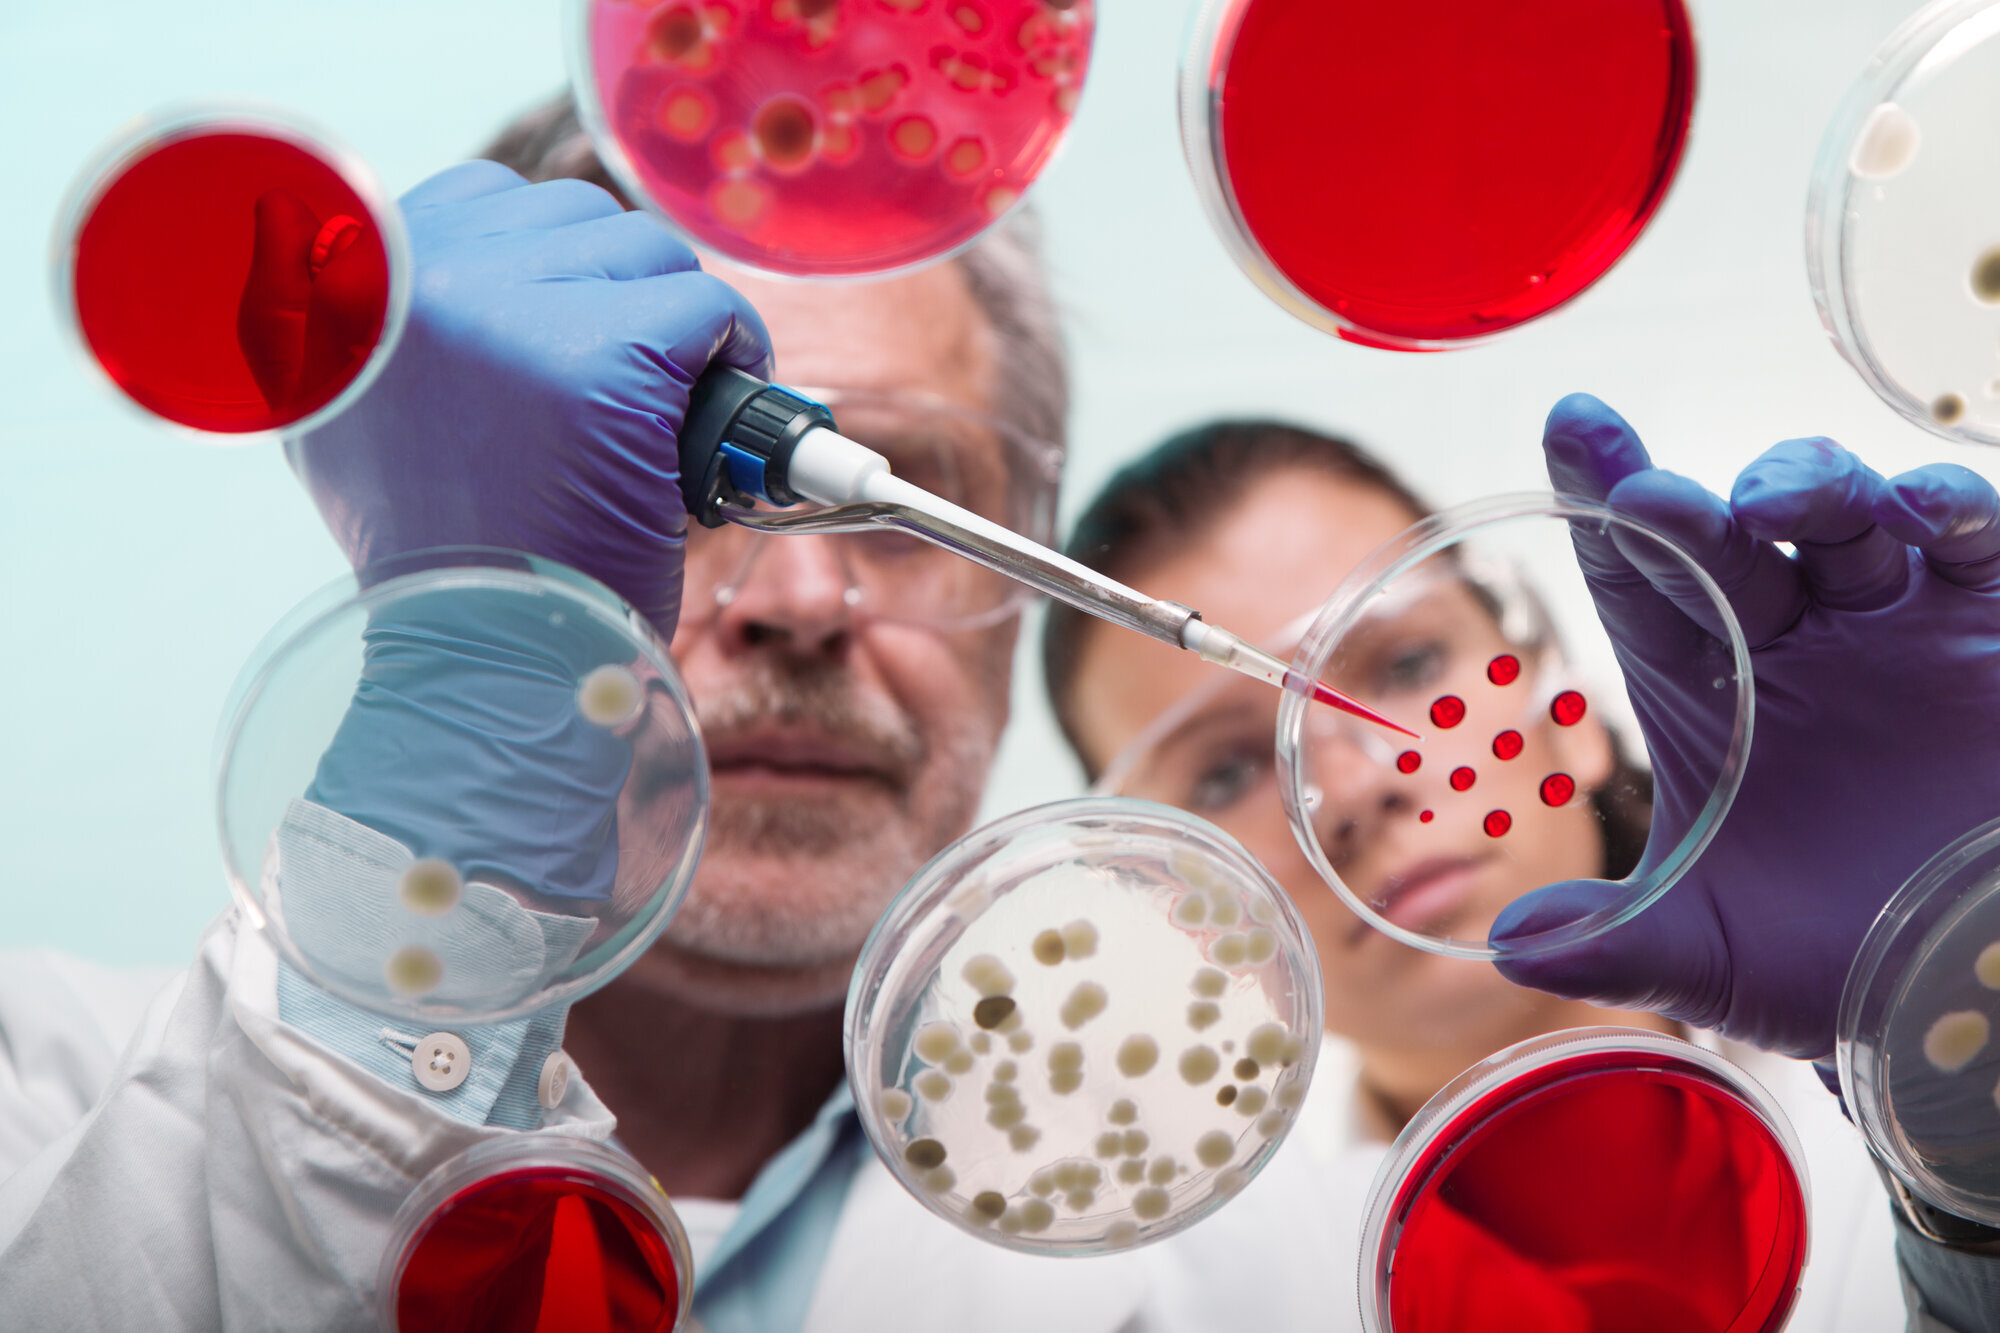
Bildet viser to forskere i et laboratorium

– Nye legemidler er dyre av en grunn
– Vi kjenner oss ikke igjen i at treg innføring av nye legemidler bare handler om pris, skriver Karita Bekkemellem, administrerende direktør i Legemiddelindustrien.
På et vanlig sykehus i dag vil legene ha tilgang til tusenvis av effektive medisiner. De aller fleste av disse er svært billige, mens noen få og nye medisiner er ganske dyre. Hvorfor er det slik?
Svaret ligger i patentordningen. Den fungerer som en samfunnskontrakt mellom de private legemiddelselskapene og helsesektoren.
Nye legemidler kan beskyttes av patent i noen få år hvor prisene er høye. Det skjer mot at patentet oppheves etter noen år og at legemiddelet dermed fritt kan produseres så lenge menneskeheten trenger det.
En økonomisk risikosport
Mandag 26. juli publiserte en rekke beslutningstakere i helsevesenet en kronikk i Aftenposten med tittelen «Hvorfor innføres ikke alle nye legemidler?».
(Kronikken ble også publisert i Sykepleien 2. august. [red.anm.])
Kronikken har flere gode poeng om innføring av nye legemidler og prioriteringer. Men det er også noen bekymringsfulle argumenter som vi må imøtegå.
Det første er en forventning om at prisen på et nytt legemiddel skal være et resultat av innsatsen som er lagt ned i utviklingen av dette konkrete legemiddelet.
De som kjenner til legemiddelutvikling i legemiddelselskaper, vet at dette er et meningsløst mål. Legemiddelutvikling er en økonomisk risikosport. De aller fleste prosjekter lander på nesen, og noen få prosjekter blir til vellykkede og effektive behandlinger.
Et eksempel på dette er flere tiårs satsing på effektiv demensbehandling. Enorme beløp er investert i legemiddelforskning, så langt uten betydelige resultater. Denne satsingen må og skal fortsette. Men hvor skal investeringene komme fra?
Blant annet fra legemiddelselskaper, som må tjene penger på behandlingene de lanserer i dag, slik at de kan forske videre på morgendagens medisiner.
Handler ikke bare om pris
Det andre store problemet er at vi ikke kjenner oss igjen i at treg innføring av nye legemidler bare handler om pris.
Tilbakemeldingene fra flere av våre medlemmer peker på at det snarere er en påfallende manglende interesse for å finne raske og effektive løsninger i forhandlinger om nye legemidler.
I dagens system vurderes helsegevinst på gruppenivå, tilrettelagt for større pasientgrupper med store mengder medisinsk data. Men med moderne, persontilpassede behandlinger vil dette være umulig. Beregning av helsegevinst vil være vanskeligere.
Dette er utfordringer som krever nye betalingsløsninger som bedre fordeler risiko og usikkerhet mellom leverandør og helsevesen.
Slike løsninger blir ofte omtalt i rosende ordelag på politisk nivå. I praksis ser vi dessverre lite vilje i helsevesenet til å bli mer fremoverlente i å prøve ut nye finansieringsløsninger.
Innovative løsninger
Legemiddelindustrien har lagt frem over 80 forslag til nye pris- og betalingsløsninger. Bruk av nye prisløsninger vil kunne gi Beslutningsforum flere verktøy mens de fortsatt kan beholde kontroll.
Vi ønsker tettere dialog med beslutningstakerne slik at vi kan finne frem til flere innovative løsninger i fellesskap – og dermed nå de politiske målene om å innføre målrettet, innovativ behandling.
Legemiddelindustrien og helsevesenet har en sterk felles interesse i å sikre at norske pasienter ikke går glipp av nye behandlingsmuligheter.
Innlegget ble først publisert av Aftenposten.
























0 Kommentarer